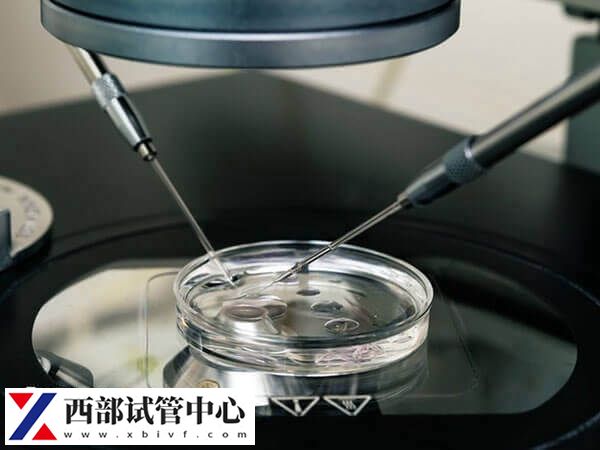
试管婴儿移植冻胚成功率

试管婴儿冻胚移植全过程解析,第一步收集胚胎!
试管婴儿技术是一种辅助生殖技术,旨在帮助那些无法自然受孕的夫妻实现怀孕。移植是试管婴儿技术的最后一步,而试管冻胚移植则是一种最常见的移植方式之一。
试管冻胚移植过程
收集胚胎
在试管婴儿技术中,女性需要在排卵期接受荷尔蒙治疗以促进卵巢排放卵子,一旦排卵成功,医生会使用超声波引导下的小针将卵子收集起来,收集到的卵子将被放置在培养皿中与精子结合进行受精。,在受精后,医生会将受精卵培养至3-5天,直到它发育成为具有8个细胞的胚胎。在这个时间段内,医生会仔细检查胚胎的发育状况以及胚胎的数量和质量,只有质量合格的胚胎才能被选择进行试管冻胚存储。
冷冻胚胎
一旦选择合格的胚胎,医生会将其置于液氮中进行冷冻保藏,以便以后使用,冻结胚胎是试管婴儿技术中的一项常见实践,它可以使患者有更多时间来决定何时进行移植,也可以提供备用胚胎以用于进一步的治疗。
解冻胚胎
当患者准备好进行试管冻胚移植时,医生会从冷冻保藏中取出胚胎并进行解冻。这个过程需要非常小心,以确保胚胎不受损,不同的冷冻方法不仅冷冻原理有差别,且胚胎装载的方式也完全不同,因此解冻时也需采用不同的解冻方法。

移植胚胎
一旦胚胎解冻成功,医生会使用非常细的管子将胚胎小心地植入患者的子宫内,这个过程通常是痛苦轻微的,不需要全身麻醉,患者需要在移植后接受一些药物以促进胚胎的着床和生长,一般情况下,如果患者的卵巢功能较好,并且子宫内膜厚度也比较好,则可以移植2-3个胚胎;但如果患者的卵巢功能较差,并且子宫内膜比较薄,则可能只能移植1个胚胎。
进行妊娠测试
在移植后的两周左右,患者需要进行妊娠测试以确认是否怀孕。如果怀孕成功,医生会建议患者进行进一步的检查以确保胚胎安全着床和发育。 总的来说,试管冻胚移植是一项非常成功的辅助生殖技术,它可以帮助无法自然受孕的夫妻实现他们的梦想。如果你正在考虑进行试管婴儿治疗,建议你与专业的医生进行咨询和讨论,以了解更多有关此项治疗过程的详细信息。





